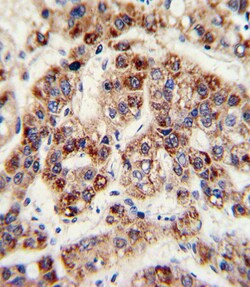
Invitrogen OTC Polyclonal Antibody 400 &mu;L; Unconjugated:Antibodies,

missing translation for 'onlineSavingsMsg'
Learn More
Learn More
Invitrogen™ OTC Polyclonal Antibody
Rabbit Polyclonal Antibody
Brand: Invitrogen™ PA535324
This item is not returnable.
View return policy
Description
This antibody is predicted to react with bovine, mouse, porcine and rat based on sequence homology.
This nuclear gene encodes a mitochondrial matrix enzyme. Missense, nonsense, and frameshift mutations in this enzyme lead to ornithine transcarbamylase deficiency, which causes hyperammonemia. Since the gene for this enzyme maps close to that for Duchenne muscular dystrophy, it may play a role in that disease also.
Specifications
| OTC | |
| Polyclonal | |
| Unconjugated | |
| OTC | |
| AI265390; OCTD; ornithine carbamoyltransferase; ornithine carbamoyltransferase, mitochondrial; Ornithine transcarbamylase; Otc; OTCase; Sf; sparse fur; spf | |
| Rabbit | |
| Antigen affinity chromatography, Protein A | |
| RUO | |
| 18416, 25611, 5009 | |
| Store at 4°C short term. For long term storage, store at -20°C, avoiding freeze/thaw cycles. | |
| Liquid |
| Flow Cytometry, Immunohistochemistry (Paraffin), Western Blot | |
| 0.5 mg/mL | |
| PBS with 0.09% sodium azide; pH 7.4 | |
| P00480, P00481, P11725 | |
| OTC | |
| KLH conjugated synthetic peptide between 71-98 amino acids of human OTC. | |
| 400 μL | |
| Primary | |
| Human, Mouse, Rat | |
| Antibody | |
| IgG |
Product Content Correction
Your input is important to us. Please complete this form to provide feedback related to the content on this product.
Product Title
Spot an opportunity for improvement?Share a Content Correction